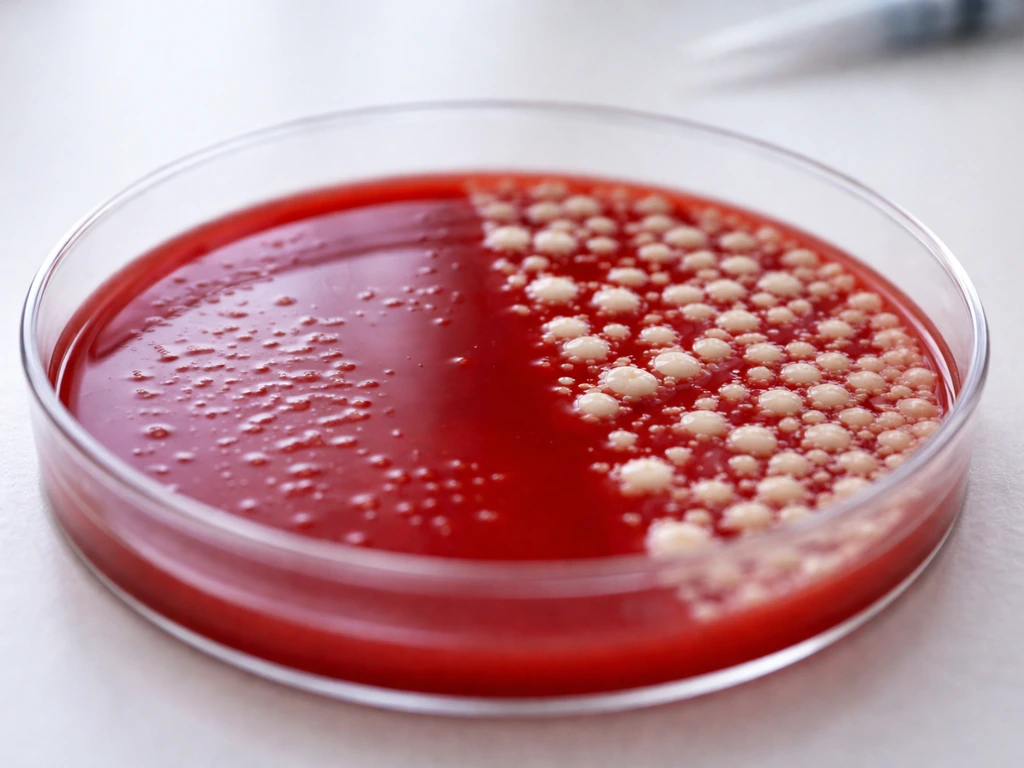
Close-up of two contrasting bacterial colony growth patterns on blood agar, showing different growth intensity
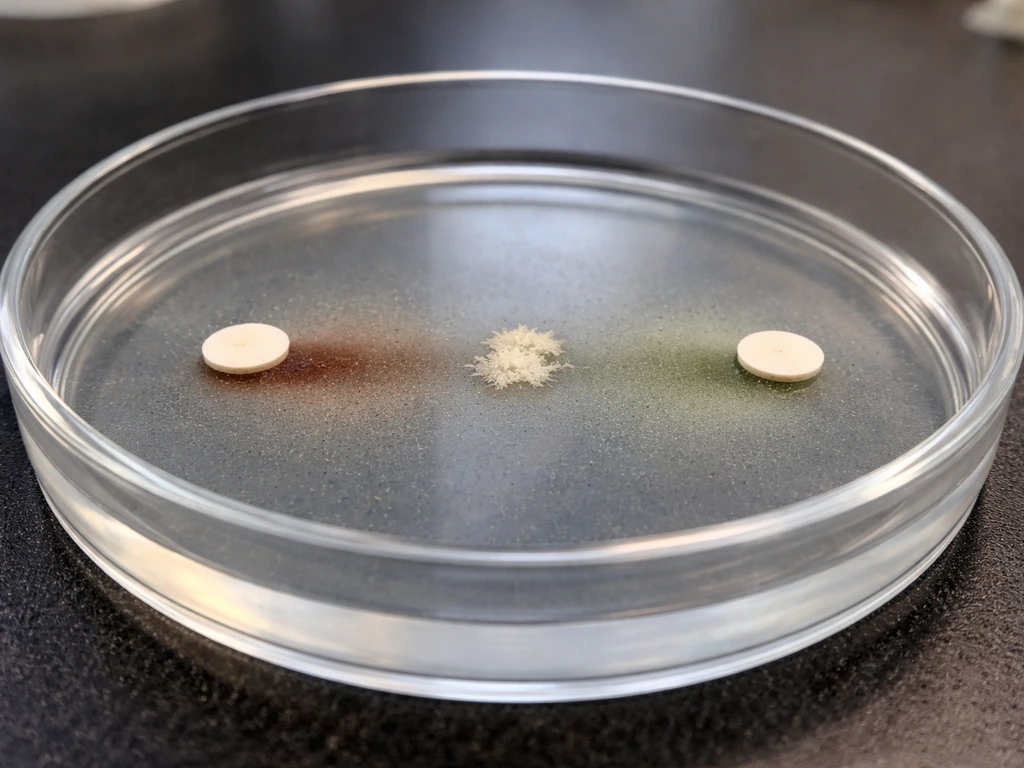
Close-up of two lab culture discs with faint diffusion trails toward small bacterial growth on agar.
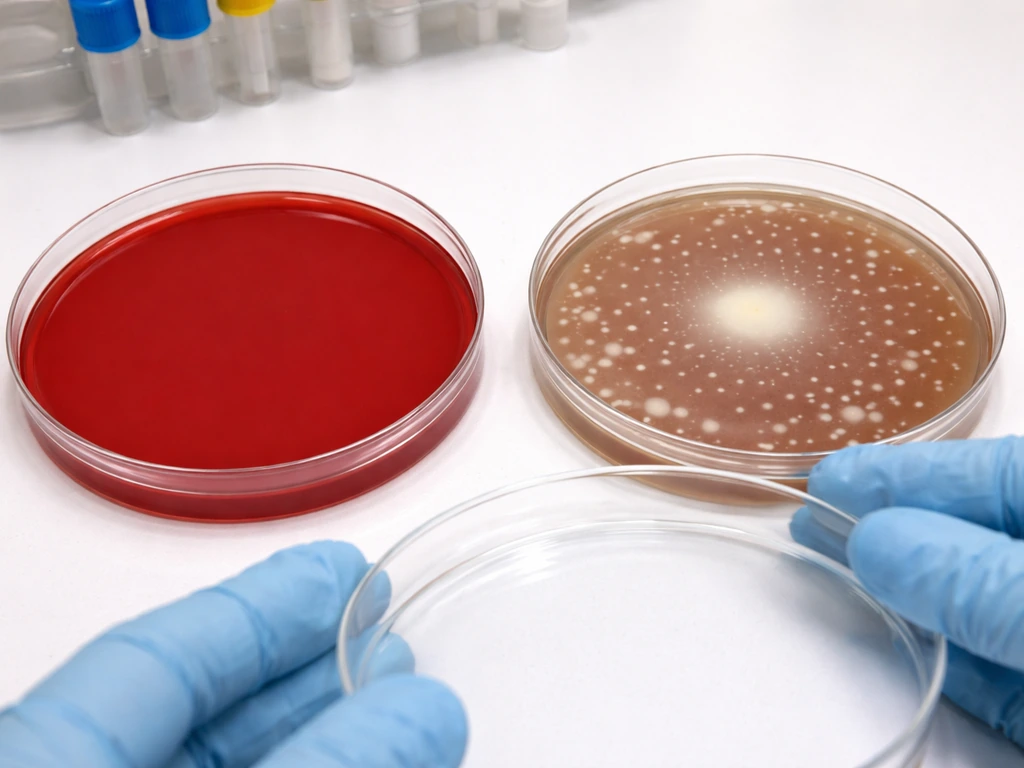
Blood agar plates: one shows no colonies, the other shows satellite colonies around a main colony.

The short answer: H. influenzae will not grow as proper colonies on standard unsupplemented blood agar. H. parainfluenzae may produce faint satellite growth on blood agar, but neither species will give you reliable, confluent colonies the way they would on chocolate agar. If you streaked a plate today and got nothing, or only tiny dots near another organism, that result is expected and meaningful, not a contamination issue or a failed plate.
Does Haemophilus influenzae Grow on Blood Agar? Guide
H. influenzae and H. parainfluenzae on blood agar: the direct answer
H. influenzae requires two growth factors: hemin (called factor X) and NAD (called factor V). Standard blood agar does not reliably supply both in accessible form, so H. influenzae will not produce visible confluent colonies on it. The only way you will see any growth at all is as satellite colonies, tiny pinpoint colonies that appear near other bacteria that have lysed the red blood cells in the agar, releasing hemin. Even then, this is marginal, opportunistic growth rather than true culture success.
H. parainfluenzae is a different story in one important way: it only requires V factor (NAD), not X. Because NAD is actually released into blood agar by red blood cells, H. parainfluenzae has better access to what it needs on blood agar than H. influenzae does. You may see satellite colonies of H. parainfluenzae around feeder organisms like Staphylococcus aureus on blood agar, but you still will not get the reliable, consistent growth that makes identification practical. For either species, blood agar alone is not a suitable primary isolation medium.
What blood agar actually provides (and where it falls short)
Blood agar is a nutrient-rich base (usually tryptic soy or Columbia agar) with intact red blood cells added after autoclaving. The intact cells stay whole, which is important for differential purposes like beta-hemolysis, but it also means that most of what is locked inside those cells stays locked inside. For Haemophilus, that matters a lot.
NAD (V factor) is present in blood agar in a usable form because red blood cells do release it into the surrounding medium, but there is a catch: blood also contains NADase, an enzyme that degrades NAD. This makes NAD availability in standard blood agar unreliable and inconsistent, especially when plates are freshly poured or stored improperly.
Hemin (X factor) is the bigger problem. Hemin is bound tightly inside intact red blood cells. It simply does not diffuse out into the agar in a usable form unless those cells are physically disrupted. This is exactly why chocolate agar works: the blood is heated during preparation (around 80°C), which lyses the red blood cells and releases hemin into the medium. Blood agar skips that step, so hemin stays trapped. No accessible hemin means no growth for H. influenzae.
Why hemin (X) and NAD (V) are the keys to Haemophilus growth
Hemin and NAD are not optional nutrients for Haemophilus, they are absolute requirements. Hemin is used in the biosynthesis of iron-containing enzymes. NAD is essential as an electron carrier in metabolic reactions. Without both, H. influenzae simply cannot complete the biochemical processes it needs to divide and form a colony.
H. parainfluenzae, as noted, only needs V factor. Its X factor pathway is functional without external supplementation. This is the key biochemical difference between the two species, and it directly explains why H. parainfluenzae has a slightly better chance of showing up on blood agar than H. influenzae does, even if neither gives you a practical, reliable result.
| Species | Requires X (Hemin) | Requires V (NAD) | Grows on Blood Agar | Grows on Chocolate Agar |
|---|---|---|---|---|
| H. influenzae | Yes | Yes | No (satellite only near feeder organisms) | Yes, reliably in ~24h |
| H. parainfluenzae | No | Yes | Faint satellite growth possible | Yes, reliably in ~24h |
Understanding this table is the foundation for interpreting any result you get off a blood agar plate. If you see nothing, that is the expected outcome for H. influenzae. If you see a few pinpoint colonies near an S. aureus streak, that satellite pattern is a diagnostic clue, not a coincidence. Because chocolate agar lyses red blood cells to release hemin and provides NAD, Staphylococcus aureus does not need chocolate agar to grow does staphylococcus aureus grow on chocolate agar.
Incubation conditions that change what you see
Even on the right medium, you will miss Haemophilus colonies if your incubation setup is off. The standard recommendation is 35 to 37°C in a CO2-enriched atmosphere, ideally 5% CO2 or a candle jar if a dedicated incubator is not available. CO2 stimulates growth and improves recovery, especially on suboptimal media. At ambient CO2 with room air, colony development is slower and less reliable.
Time matters more than people expect. On chocolate agar with correct CO2, H. influenzae and H. parainfluenzae colonies typically develop within 24 hours and become clearly visible by that point. On blood agar, any satellite colonies that do appear may take longer or remain extremely small. On that medium, you can typically see growth from Haemophilus species after proper incubation conditions chocolate agar. Reading a blood agar plate at 18 hours and calling it negative is a genuine risk for missing growth. Hold plates for at least 48 hours before making a final call, especially if your clinical suspicion for Haemophilus is high.
Atmosphere, temperature, and incubation time each act as independent variables. A perfectly prepared chocolate agar plate incubated without CO2 at 33°C for only 18 hours can still give you a weak or missed result. Get all three parameters right before trusting a negative.
Common lab pitfalls: reading no growth vs satellite growth correctly
The most common mistake is treating "no growth on blood agar" as a true negative for Haemophilus. It is not. It is the expected outcome. If you are using blood agar as your only isolation medium for a specimen with suspected H. influenzae, you have already set yourself up for a false negative before the plate went into the incubator.
Satellite growth is easy to overlook. Satellite colonies are tiny, often 0.5 mm or smaller, and they appear only in the zone near feeder organisms. If your specimen was plated as a pure culture or you did not include a cross-streak of S. aureus, you will not see satellite colonies at all, and there will be nothing to interpret. Satellite growth is also not useful for quantification or further testing, so even finding it on blood agar should send you to a supplemented medium next.
A few other things worth checking when your result does not make sense:
- Check media age: old blood agar plates lose NAD activity faster due to NADase degradation, reducing even the partial V factor availability.
- Check the CO2 supply: if the incubator CO2 failed or the candle jar was not well sealed, recovery drops sharply.
- Check inoculum quality: too-light an inoculum on an already-marginal medium will yield no growth even for organisms that can technically grow.
- Check that you have the right species: if satellite growth appears, confirm factor requirements with X and V disk testing before assuming the organism is H. influenzae.
- Do not confuse other small-colony organisms for satellite Haemophilus colonies, especially in mixed culture specimens.
What media to use and how to set up proper controls
For any specimen where Haemophilus is a possibility, chocolate agar is your primary isolation medium, full stop. It supplies both hemin and NAD in accessible form because the red blood cells have been heat-lysed during preparation. Colonies typically appear within 24 hours at 35 to 37°C in 5% CO2, and the morphology is distinct enough to flag for further identification. Some labs also use chocolate agar supplemented with IsoVitaleX or Vitox, which adds additional V factor and supports even better recovery, particularly for fastidious strains.
If you want to confirm factor requirements (which is standard practice for definitive identification), set up a blood agar plate with individual X and V factor disks placed about 10 mm apart after inoculating the plate. Incubate at 35 to 37°C in CO2 for 24 hours. Growth only near the V disk indicates V-factor dependence only (consistent with H. parainfluenzae). Growth only between both disks where the factor zones overlap indicates both X and V are required (consistent with H. influenzae). This satellite disk test is a practical, low-cost confirmation step.
For the cross-streak satellite test on blood agar: inoculate the suspect organism across the plate, then streak a line of S. aureus (a known beta-hemolysin producer) perpendicular to it. After 24 to 48 hours in CO2 at 35 to 37°C, look for small satellite colonies of the suspect organism growing near the S. aureus streak. This approach confirms the satellitism behavior and provides qualitative evidence of growth factor dependence, but it is still not a substitute for chocolate agar as your primary culture medium.
When setting up controls, include a known H. influenzae strain on both your blood agar and chocolate agar plates to confirm your media and incubation conditions are performing correctly. If your positive control fails to grow on chocolate agar, the problem is with your media or incubation, not the specimen. If it grows on chocolate but not on blood agar, that confirms expected behavior and gives you a reliable baseline for interpreting your test results.
It is also worth knowing that Haemophilus behavior on different selective and enriched media is a recurring theme across related organisms in clinical microbiology. Neisseria, for example, also has specific media requirements that differ between chocolate and blood agar, and chocolate agar is frequently used for fastidious organisms as a group for exactly this reason. This is the same reason Neisseria requires the right enriched medium to grow. Understanding why blood agar falls short for Haemophilus helps you apply the same reasoning to other organisms with similar factor dependencies.
Putting it all together for your lab workflow
If you are at the bench today trying to work out why your blood agar plate has nothing on it, or only faint dots near another organism, you now have the full picture. H. influenzae will not grow on standard blood agar because hemin is not accessible from intact red blood cells. If you want the practical answer for when H. influenzae does succeed, it is designed to grow on chocolate agar. H. parainfluenzae has a slightly better chance because it only needs V factor, which is partially available, but satellite growth is still inconsistent and not suitable for reliable identification.
- Switch to chocolate agar as your primary medium for any specimen where Haemophilus is suspected.
- Incubate at 35 to 37°C in 5% CO2 (or a candle jar) for at least 24 hours, and hold to 48 hours before calling negative.
- Run X and V disk testing on blood agar to confirm factor requirements and differentiate H. influenzae from H. parainfluenzae.
- Use the cross-streak S. aureus test on blood agar as a supplementary confirmation of satellitism, not as a replacement for chocolate agar.
- Include positive and negative controls on every run to verify media performance and incubation conditions.
- Consider IsoVitaleX or Vitox supplementation on chocolate agar for difficult specimens or when standard chocolate agar recovery is inconsistent.
No growth on blood agar is not a failed experiment. For H. influenzae, it is the correct result. The goal is to understand why, set up the right media, and use the satellite and disk tests as tools rather than primary culture methods.
FAQ
If I see “satellite” colonies on blood agar, does that confirm Haemophilus influenzae specifically?
Not by itself. Satellite growth on blood agar is compatible with H. influenzae or H. parainfluenzae because both can take advantage of growth factor release from nearby organisms. To distinguish them, use the X and V factor disk overlap (or confirm growth on chocolate agar with proper CO2 and time).
How long should I hold a blood agar plate before calling it negative for Haemophilus?
Don’t finalize at 18 to 24 hours. Read at least again at 48 hours when Haemophilus is clinically plausible, since any satellite growth on blood agar can be delayed and remain tiny. Early calling negative is a common way Haemophilus is missed.
Can a “failed plate” explain no growth of H. influenzae on blood agar?
Yes for the media or incubation system, but not usually for the organism behavior itself. That’s why you should run a known H. influenzae control on both chocolate and blood agar. If the control fails on chocolate, suspect problems with media preparation, CO2, temperature, or incubation time rather than assuming the specimen is negative.
What incubation CO2 level matters most if I’m using blood agar for suspected Haemophilus?
CO2 affects recovery and speed, even for fastidious organisms. Aim for 5% CO2 (or a candle jar if that’s your standard approach). At ambient room air CO2, growth, if it occurs, is slower and more easily overlooked, increasing the chance you miss satellites.
Does batch-to-batch variation in blood agar affect Haemophilus growth?
It can. Because NAD availability can be inconsistent and hemin accessibility depends on red cell integrity, differences in how fresh the blood agar is and how it was stored can change whether you see any marginal satellite growth. This is another reason chocolate agar is the preferred primary medium.
If my specimen was mixed with many bacteria, should I still try to interpret blood agar satellites?
Only qualitatively. In mixed growth, satellites can be hard to distinguish from tiny contaminants, and they can be suppressed by faster growers. If you suspect Haemophilus, prioritize re-isolation or confirm from a properly streaked culture on chocolate agar, then use factor tests if needed.
Do I need a feeder organism like Staphylococcus aureus to look for Haemophilus on blood agar?
For demonstrating satellitism, yes, practically. Satellite colonies typically appear near organisms that lyse red cells and provide hemin or create the conditions for growth factor access. If you don’t include a cross-streak feeder approach (or a known beta-hemolysin producer), you may see no satellites even when Haemophilus is present.
What’s the most common interpretation mistake when blood agar shows no colonies?
Treating “no growth on blood agar” as a true negative for H. influenzae. On standard blood agar, no confluent colonies is the expected outcome, so the correct next step is to check chocolate agar results and, if warranted, perform factor confirmation rather than concluding Haemophilus is absent.
If chocolate agar grows Haemophilus, do I need to do factor disk testing or can I rely on blood agar behavior?
Factor testing is still useful for definitive identification, especially when multiple fastidious organisms could be present or when colonies are atypical. Blood agar behavior alone, including satellites, is not reliable enough for species-level confirmation because both X and V dependencies can produce similar looking outcomes.
Can I use blood agar to quantify Haemophilus burden in a specimen?
No. Any growth on blood agar is opportunistic, small, and non-confluent, so it doesn’t correlate well with organism quantity. If quantification matters, use an appropriate primary isolation approach on supplemented media and follow your lab’s validated quantitative workflow.
Can Bacteria Grow in Vinegar? pH, Survival, and Safety Tips
Explore if bacteria can grow in vinegar, how pH and dilution affect survival, and practical food-safety storage tips.


